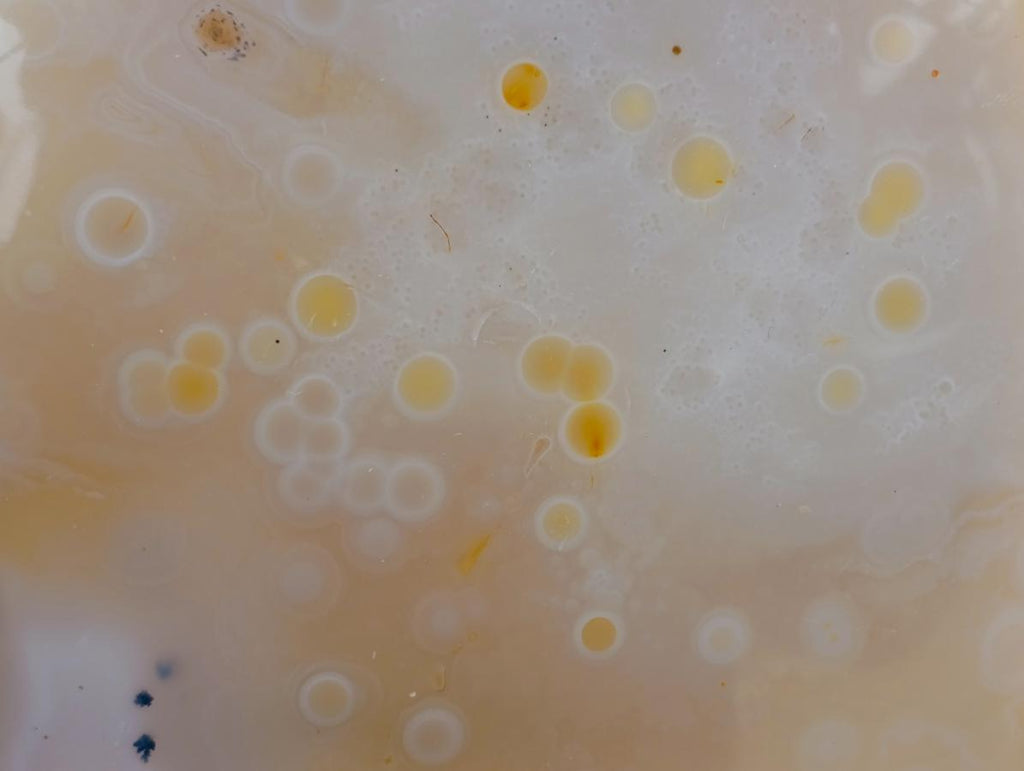
Polished Large Banded Agate Hearts x 2 From Madagascar - Toprock Gemstones and Minerals

Welcome to TOPROCKS.COM - You are shopping on our RETAIL site for worldwide customers and collectors. You are welcome to Shop and Ship any of our 20,000+ specimens with no minimum requirements. For WHOLESALE access, please Login using your 'Approved Wholesale / Trade' email address (HOW?) or email Renate@Toprocks.com

Polished Large Banded Agate Hearts x 2 From Madagascar
RETAIL PRICE
A NOTE FROM NICK
A pair of large selected beautifully polished Banded Agate hearts.
PRODUCT DESCRIPTION
Gorgeous Banded Agate from Madagascar
Banded Agate from Madagascar is a variety of Chalcedony known for its striking, layered patterns and vibrant color combinations. Characterized by bands of contrasting hues, including rich browns, creams, and earthy tones, this stone often exhibits a smooth, glossy surfaces that enhance its visual appeal.
PRODUCT FEATURES
Trigonal, Monoclinic, Banded
PRODUCT COLOUR
Grey, White, Blue, Brown
MOHS HARDNESS SCALE
6.5 - 7
PRODUCT DATA
Locality = Madagascar
Grade = Good to A Grade
Size = 118 - 143 mm